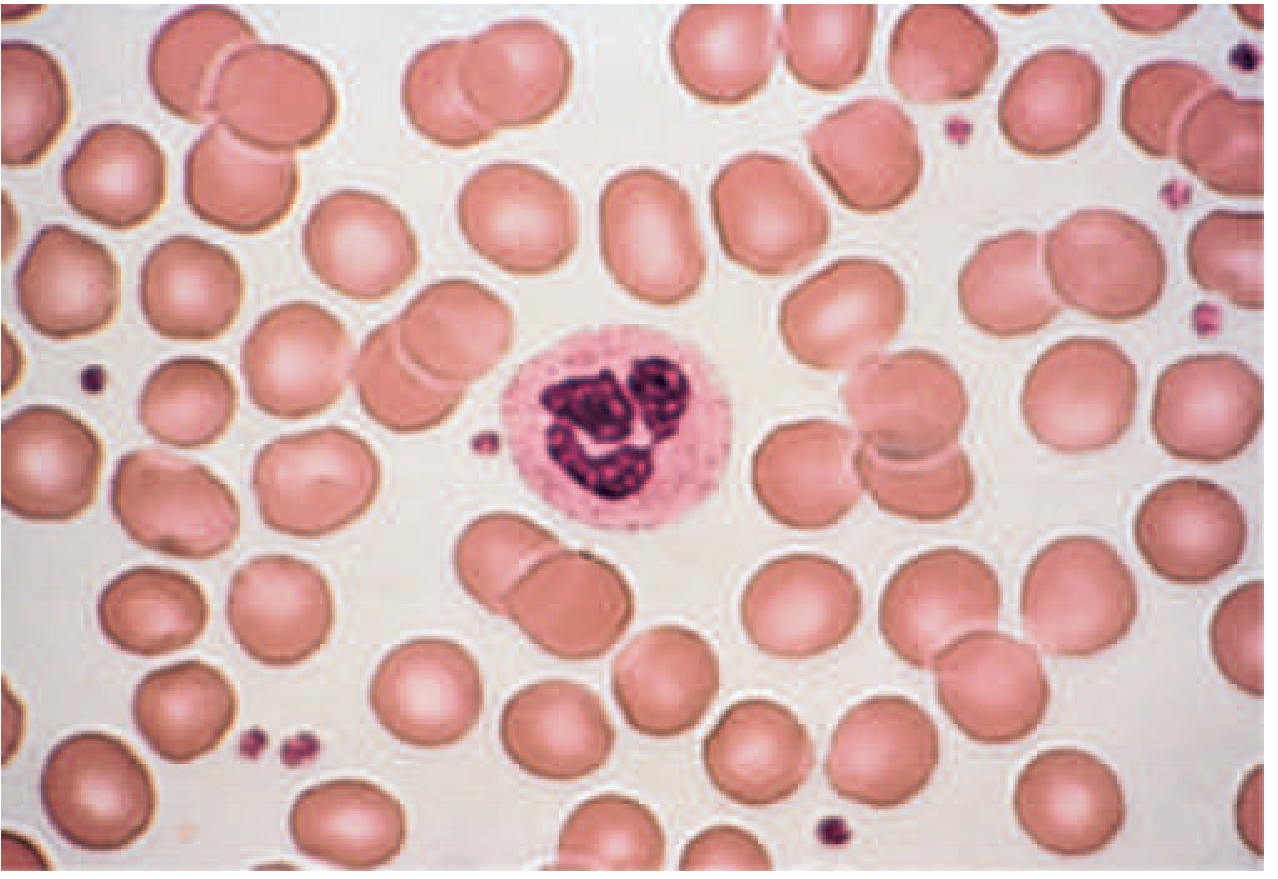
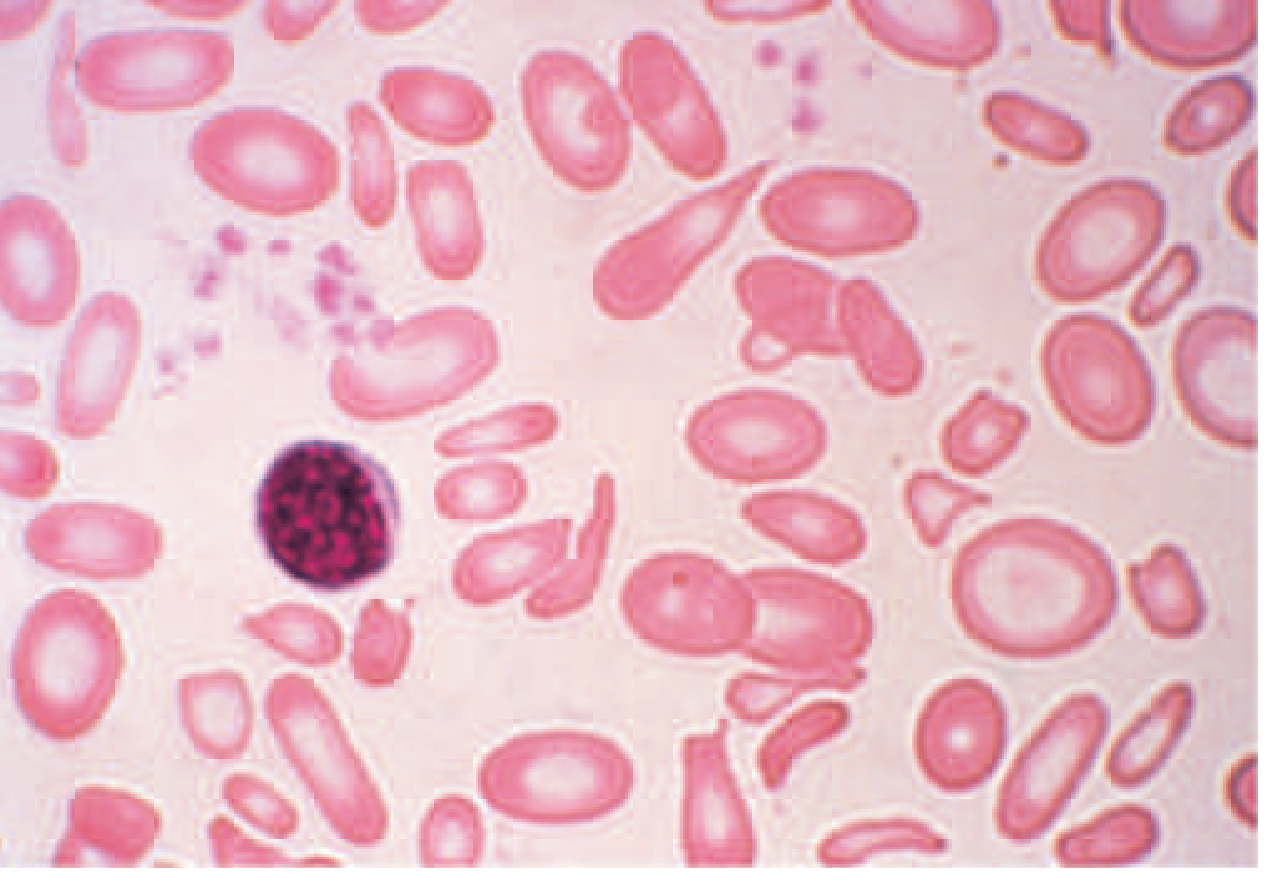

Anemia – Complete Diagnostic Approach (Stepwise) Also extract high quality images wherever necessary for showcasing any clinical findings
Reading File
Finding Sources
Finding Sources
Reading File
Reading File
Finding Sources
Reading File
Finding Sources
Finding Sources
Reading File
Reading File
Finding Sources
Reading File
Finding Sources
Searching Images
anemia blood smear peripheral smear microcytic hypochromic iron deficiency
Searching Images
sickle cell anemia target cells schistocytes spherocytes blood smear morphology
Finding Sources
Loading Image
Loading Image
Loading Image
Loading Image
Loading Image
Loading Image
Loading Image
Reading File
Now I have all the material needed. Let me compile the comprehensive stepwise diagnostic guide.
Anemia — Complete Diagnostic Approach (Stepwise)
Sources: Harrison's Principles of Internal Medicine 22E (2025), Robbins & Kumar Pathologic Basis of Disease, Goldman-Cecil Medicine, Tintinalli's Emergency Medicine
Physiologic Basis
The size of the red cell mass reflects the balance between red cell production and destruction. The master regulator is erythropoietin (EPO), produced primarily by peritubular capillary cells of the kidney in response to tissue hypoxia via the HIF-1α pathway. When hemoglobin falls below 100–120 g/L (10–12 g/dL), EPO rises proportionally. A defect in any of three components — renal EPO production, bone marrow function, or substrate supply (especially iron) — can produce anemia. — Harrison's 22E
Definition: Normal Hemoglobin/Hematocrit Values
| Population | Hemoglobin (g/dL) | Hematocrit (%) |
|---|---|---|
| Adult man | 16 (±2) | 47 (±6) |
| Adult woman (menstruating) | 13 (±2) | 40 (±6) |
| Adult woman (postmenopausal) | 14 (±2) | 42 (±6) |
| Pregnancy | 12 (±2) | 37 (±6) |
| Childhood | 12 | 36 |
| Newborn | 17 | 52 |
WHO defines anemia as Hb <13 g/dL in men, <12 g/dL in non-pregnant women, <11 g/dL in pregnant women.
Step 1 — History
The first step is a focused history:
- Previous episodes of anemia, prior iron pills or transfusions
- Family history (hemoglobinopathies, hereditary spherocytosis)
- Menstrual history: duration of periods, number of pads/tampons, large clots
- Blood donation
- Dietary history (vegetarian/vegan → B12 risk; poor diet → folate risk)
- Alcohol use, liver disease, hypothyroidism
- Symptoms pointing to underlying cause: diarrhea (celiac, IBD), bone pain (myeloma), weight loss (malignancy), neurological symptoms (B12 deficiency)
- Medications (chemotherapy, methotrexate, antiseizure drugs, ACE inhibitors, NSAIDs → GI blood loss)
- Geography/ethnicity (sickle cell, thalassemia in relevant populations)
Step 2 — Physical Examination
The exam should focus on:
- Consequences of anemia: pallor of mucosa/conjunctiva, resting tachycardia, cardiac flow murmur, dyspnea
- Clues to cause:
- Splenomegaly → hemolysis, lymphoma, portal hypertension
- Lymphadenopathy → lymphoma, leukemia
- Hepatomegaly/jaundice → hemolytic anemia, liver disease
- Glossitis, angular cheilitis, koilonychia → iron deficiency
- Neurologic signs (subacute combined degeneration) → B12 deficiency
- Petechiae/bleeding → aplastic anemia, thrombocytopenia
- Rectal exam/occult blood → GI blood loss
Step 3 — Initial Laboratory Work-Up
Complete Blood Count (CBC) with Differential
The CBC is the cornerstone. Key indices:
| Index | Normal Range | Significance |
|---|---|---|
| Hemoglobin/Hematocrit | See above | Defines severity |
| MCV (Mean Corpuscular Volume) | 80–100 fL | Size classification |
| MCH | 27–33 pg | Hemoglobin content per cell |
| MCHC | 32–36 g/dL | Hemoglobin concentration |
| RDW (Red Cell Distribution Width) | 11.5–14.5% | Anisocytosis |
| WBC + differential | — | Pancytopenia, leukocytosis |
| Platelet count | — | Bone marrow function |
Reticulocyte Count — The Critical Branching Point
The absolute reticulocyte count (ARC) is the most important first indicator of anemia mechanism:
- Elevated ARC (>100,000/μL) → Bone marrow is responding → anemia due to increased loss or destruction (bleeding or hemolysis)
- Low/normal ARC (<50,000/μL) → Bone marrow is failing to respond → anemia due to impaired production (hypoproliferative)
The reticulocyte production index (RPI) = [reticulocyte % × Hct/45] / maturation factor. An RPI <2 indicates hypoproliferation; RPI >3 indicates hyperproliferation.
Step 4 — Peripheral Blood Smear (MANDATORY)
"A review of the blood smear is a crucial part of any evaluation for anemia as changes in red cell morphology can point to specific causes of anemia." — Harrison's 22E
Normal Blood Smear (Reference)
Key Red Cell Morphology and Diagnostic Significance
| Morphology | Pathophysiology | Disease States |
|---|---|---|
| Microcytosis / Hypochromia | Inadequate hemoglobinization | Iron deficiency, thalassemia, sideroblastic anemia, anemia of chronic disease |
| Macro-ovalocytes | Nuclear-cytoplasmic dyssynchrony | B12 / folate deficiency, myelodysplasia, chemotherapy |
| Spherocytes | Loss of red cell membrane | Hereditary spherocytosis, autoimmune hemolytic anemia |
| Schistocytes | Mechanical fragmentation | TTP/HUS, DIC, prosthetic heart valve hemolysis, march hemoglobinuria |
| Sickle cells | Hemoglobin polymerization | Sickle cell disease (HbSS, HbSC) |
| Target cells | Relative membrane excess | Liver disease, thalassemia, hemoglobinopathies |
| Polychromasia | Persistence of RNA in reticulocytes | Hemolytic anemia, blood loss |
| Basophilic stippling | Pathologic polyribosome precipitation | Thalassemia, lead poisoning |
| Howell-Jolly bodies | Nuclear remnants | Asplenia, functional hyposplenism |
| Teardrop cells + nucleated RBCs | Marrow architecture disruption | Myelofibrosis, myelophthisic anemia |
| Hypersegmented neutrophils | Impaired DNA synthesis | B12/folate deficiency (megaloblastic anemia) |
Step 5 — MCV-Based Classification and Targeted Workup
5A — Microcytic Anemia (MCV < 80 fL)
Caused by any process that interferes with hemoglobin production — less hemoglobin → smaller red cells.
Differential: Iron deficiency · Thalassemia · Anemia of chronic disease/inflammation · Sideroblastic anemia · Lead poisoning
Peripheral Smear: Severe Iron Deficiency Anemia
Key Laboratory Panel for Microcytic Anemia:
| Test | Iron Deficiency | Anemia of Inflammation | Thalassemia | Sideroblastic Anemia |
|---|---|---|---|---|
| Smear | Micro/hypo | Normal or micro/hypo | Micro/hypo + targeting | Variable |
| Serum iron (μg/dL) | <30 | <50 | Normal–high | Normal–high |
| TIBC (μg/dL) | >360 | <300 | Normal | Normal |
| Transferrin saturation | <10% | 10–20% | 30–80% | 30–80% |
| Ferritin (μg/L) | <15 | 30–200 | 50–300 | 50–300 |
| Hb electrophoresis | Normal | Normal | Abnormal (β-thal); may be normal (α-thal) | Normal |
| RDW | High (anisocytosis) | Normal | Low (homogeneous cells) | Variable |
Key distinguishing clue: RDW is high in iron deficiency (anisocytosis) but low in thalassemia (uniform microcytosis). — Harrison's 22E
Ferritin <30 μg/L = depleted iron stores. Ferritin >200 μg/L = some tissue stores remain. However, ferritin is an acute-phase reactant — it may be falsely elevated in inflammation even with concurrent iron deficiency.
5B — Macrocytic Anemia (MCV > 100 fL)
Two morphologic subtypes guide further workup:
Oval Macrocytes (Megaloblastic pattern)
Caused by defects in DNA synthesis → abnormal nuclear-cytoplasmic maturation (megaloblasts in marrow).
- Causes: Vitamin B12 deficiency · Folate deficiency · Chemotherapy agents (hydroxyurea, methotrexate) · Myelodysplastic syndrome (MDS)
Round Macrocytes (Non-megaloblastic)
Caused by membrane defects (cholesterol/phospholipid changes).
- Causes: Alcohol use · Liver disease · Hypothyroidism · Reticulocytosis · Dysproteinemia · Smoking · Hypoxia
Peripheral Smear + Bone Marrow: Severe Megaloblastic Anemia

Macrocytic Workup:
- Blood smear — oval vs. round macrocytes? Hypersegmented neutrophils?
- If megaloblastic pattern: Serum B12 + serum folate / RBC folate
- If B12 low: anti-intrinsic factor antibodies (pernicious anemia), Schilling test if needed
- If B12/folate normal with macro-ovalocytes: bone marrow biopsy (suspect MDS)
- If round macrocytes: check TSH, LFTs, alcohol history
5C — Normocytic Anemia (MCV 80–100 fL)
The broadest and most heterogeneous category. Workup is mechanistically driven.
Differential:
- Aplastic anemia · Pure red cell aplasia
- Renal disease (EPO deficiency)
- Anemia of inflammation/chronic disease
- Endocrinopathies (hypothyroidism, Addison's)
- Marrow infiltration (myeloma, metastases, granulomas)
- Stem cell defects (leukemia, MDS)
- Acute blood loss/early iron deficiency
Normocytic Workup:
- Reticulocyte count (see Step 4 above)
- Renal function (Cr/eGFR), EPO level
- TSH, cortisol (endocrine causes)
- Serum protein electrophoresis (SPEP) for myeloma
- LDH, haptoglobin, bilirubin (if hemolysis suspected)
- Consider bone marrow exam if no clear cause found
Step 6 — Reticulocyte-Guided Mechanistic Workup
6A — High Reticulocyte Count → Hemolysis / Blood Loss
Rule out bleeding first (clinical history, occult stool blood, imaging). If no bleeding:
Hemolysis Workup:
| Test | Finding in Hemolysis |
|---|---|
| LDH | Elevated (abundant in RBCs) |
| Serum haptoglobin | Low (binds free Hb; consumed) |
| Indirect bilirubin | Elevated |
| Urine hemoglobin/hemosiderin | Positive in intravascular hemolysis |
| Direct Antiglobulin Test (DAT/Coombs) | Positive → immune-mediated (AIHA) |
| Peripheral smear | Spherocytes (AIHA, HS), schistocytes (TTP/HUS), sickle cells |
| Osmotic fragility | Increased in hereditary spherocytosis |
| G6PD assay | Low in G6PD deficiency |
| Hb electrophoresis | Abnormal in hemoglobinopathies |
| Flow cytometry (CD55/CD59) | Absent in PNH |
Autoimmune Hemolytic Anemia — Peripheral Smear

Sickle Cell Disease — Peripheral Smear

6B — Low Reticulocyte Count → Hypoproliferative (Underproduction)
"At least 75% of all cases of anemia are hypoproliferative in nature." — Harrison's 22E
Sub-classification by mechanism:
| Mechanism | Key Features | Diagnostic Test |
|---|---|---|
| Nutritional (Iron) | Microcytic, low ferritin, high TIBC | Ferritin, serum iron, TIBC |
| Nutritional (B12/Folate) | Macrocytic, hypersegmented PMNs | Serum B12, folate, MMA, homocysteine |
| Renal (EPO deficiency) | Normocytic, eGFR <30–60 | Creatinine, eGFR, EPO level |
| Anemia of inflammation | Normocytic or mild microcytic; high ferritin, low TIBC | CRP, ESR, ferritin, underlying disease |
| Marrow replacement | Myelophthisic picture (teardrops, nRBCs, leukoerythroblastosis) | BM biopsy |
| Aplastic anemia | Pancytopenia, hypocellular marrow | BM biopsy (hypocellular) |
| Pure red cell aplasia | Very low retics, normal WBC/plt, absent erythroid precursors | BM biopsy, parvovirus B19 serology |
| MDS | Macro-ovalocytes, dysplastic WBCs/platelets | BM biopsy + cytogenetics |
| Leukemia | Pancytopenia, blasts on smear | BM biopsy + molecular testing |
Anemia of Chronic Inflammation — Mechanism
The predominant mechanism is hepcidin upregulation by inflammatory cytokines (TNF, IL-6). Hepcidin blocks:
- Iron absorption from the gut
- Iron release from macrophages/stores → Functional iron deficiency despite normal/high stores. EPO levels are also suppressed by cytokines. Laboratory: normocytic or mild microcytic anemia; ferritin high (acute-phase reactant); serum iron low; TIBC low (distinguishes from true iron deficiency where TIBC is high). — Harrison's 22E, Robbins & Kumar
Step 7 — Bone Marrow Examination
Indications (from Histology: A Text and Atlas):
- Unexplained severe anemia
- Abnormal peripheral blood smear morphology suggesting marrow pathology
- Suspected aplastic anemia, MDS, or leukemia
- Circulating nucleated red blood cells
- Myelophthisic picture (teardrop cells + leukoerythroblastosis)
- Staging of lymphoma or certain malignancies
- Macro-ovalocytes with normal B12/folate (suspect MDS)
- Marrow infiltration suspected (myeloma, metastases, granulomas)
Bone marrow examination includes aspirate (cytology + flow cytometry) and trephine biopsy (cellularity, architecture, molecular testing).
Step 8 — Additional Targeted Tests by Clinical Context
| Clinical Suspicion | Additional Tests |
|---|---|
| Pernicious anemia | Anti-intrinsic factor Ab, anti-parietal cell Ab |
| Thalassemia | Hb electrophoresis, α-gene deletion (PCR), family study |
| Hemoglobinopathy | Hb electrophoresis, sickling test |
| PNH | Flow cytometry (CD55, CD59 deficiency) |
| TTP/HUS | ADAMTS13 activity, schistocytes, platelet count, creatinine |
| Lead poisoning | Blood lead level, basophilic stippling on smear |
| Liver disease | LFTs, coagulation panel |
| Hypothyroidism | TSH |
| Myeloma | SPEP, UPEP, serum free light chains, BM biopsy |
| Autoimmune | ANA, RF (underlying connective tissue disease) |
Summary Algorithm
Hemoglobin low?
│
▼
History + Physical → Severity, Symptoms, Clues to Cause
│
▼
CBC + Reticulocyte Count + Peripheral Blood Smear
│
├── Retic ↑ (>100K) ─── Bleeding? ── YES → GI workup, imaging
│ │
│ NO → Hemolysis workup:
│ LDH ↑, Haptoglobin ↓, Indirect bili ↑
│ DAT (Coombs), smear morphology
│ G6PD, Hb electrophoresis, PNH screen
│
└── Retic ↓ / normal ── MCV?
│
┌───────────┼──────────────┐
▼ ▼ ▼
Microcytic Normocytic Macrocytic
(MCV <80) (MCV 80–100) (MCV >100)
│ │ │
Ferritin + Renal Fn, Smear →
Serum Fe + EPO level, Oval macros?
TIBC + TSH, SPEP, → B12/Folate
Hb electro BM if needed Round macros?
RDW → Alcohol/Liver/
(↑ IDA, Thyroid
↓ Thal) Normal B12/folate
+ oval macros?
→ BM (MDS)
Comparison: Iron Deficiency vs. Anemia of Inflammation (Common Clinical Dilemma)
| Feature | Iron Deficiency | Anemia of Inflammation |
|---|---|---|
| Ferritin | ↓ (<15 μg/L) | Normal to ↑ (30–200) |
| Serum iron | ↓ | ↓ |
| TIBC | ↑ (>360) | ↓ (<300) |
| Transferrin sat | <10% | 10–20% |
| Hepcidin | ↓ | ↑ |
| RBC morphology | Micro/hypo | Normocytic or mildly micro |
| Cause | Blood loss, malabsorption, poor intake | Infection, cancer, RA, IBD |
When both conditions coexist (common), ferritin may be falsely normal. The soluble transferrin receptor (sTfR) or sTfR/log ferritin index can help — it rises in true iron deficiency but not in inflammation alone.
Macrocytic Anemia: B12 vs. Folate vs. MDS
| Feature | B12 Deficiency | Folate Deficiency | MDS |
|---|---|---|---|
| Smear | Oval macrocytes, hyperseg PMNs | Same | Oval macrocytes ± dysplasia |
| Serum B12 | Low (<200 pg/mL) | Normal | Normal |
| Serum folate | Normal | Low | Normal |
| Homocysteine | ↑ | ↑ | Normal |
| Methylmalonic acid (MMA) | ↑ (B12-specific) | Normal | Normal |
| Neurological signs | YES (posterior column) | No | No |
| Bone marrow | Megaloblastic | Megaloblastic | Dysplastic (ringed sideroblasts, etc.) |
Severity Classification
| Severity | Hemoglobin |
|---|---|
| Mild | 10–12 g/dL (women) / 10–13 g/dL (men) |
| Moderate | 8–10 g/dL |
| Severe | 6–8 g/dL |
| Very severe / life-threatening | <6 g/dL |
Key Points
- Reticulocyte count is the single most important test after the CBC — it divides anemia into hyperproliferative (hemolysis/bleeding) vs. hypoproliferative (underproduction).
- Peripheral blood smear is mandatory and often diagnostic without further testing.
- MCV classifies by morphology and drives targeted testing in hypoproliferative anemia.
- RDW distinguishes iron deficiency (high, anisocytosis) from thalassemia (low, uniform cells).
- Ferritin is an acute-phase reactant — it can be normal or high in combined iron deficiency + inflammation.
- Hepcidin is the master iron regulator — elevated in anemia of inflammation; suppressed in iron deficiency.
- Bone marrow biopsy is reserved for unexplained anemia with myelophthisic features, pancytopenia, suspected malignancy, or when initial workup is unrevealing.
- At least 75% of all anemia is hypoproliferative; the most common cause globally is iron deficiency.
— Harrison's Principles of Internal Medicine 22E (2025, McGraw Hill) | Robbins, Cotran & Kumar Pathologic Basis of Disease | Goldman-Cecil Medicine | Tintinalli's Emergency Medicine
Create a single page note taking like image of this content and add infographics and illustrations wherever needed for quick understanding
Checking Date & Time
Running Command
Running Command
Writing File
Running Command
Reading File
Running Command
Loading Image
Running Command
Running Command
Your single-page diagnostic note is ready!
Anemia Diagnostic Note
Image · PNG
Here's what's packed into the note (11 labeled sections):
| # | Section | Visual Style |
|---|---|---|
| 1 | Header + Normal Hb values | Deep navy banner with colour-coded reference strip |
| 2 | History + Physical Exam | Side-by-side tinted panels |
| 3 | CBC Indices | Quick-reference bar with normal ranges |
| 4 | Reticulocyte Count – Master Branch Point | Central red diamond → High (red) / Low (blue) branches with sub-boxes |
| 5 | MCV Classification | 3-column colour-coded grid (micro/normo/macro) with cause + test per entry |
| 6 | Iron Studies Differential Table | 5-column table (IDA vs AoI vs Thal vs Sideroblastic) with red highlights |
| 7 | Peripheral Smear Morphology Guide | 8 morphology tiles with coloured left-accent and → diagnosis |
| 8 | Hemolysis Workup | 8 test cards (LDH, haptoglobin, DAT, G6PD, PNH screen, etc.) |
| 9 | B12 vs Folate vs MDS Table | 7-row differential with MMA/homocysteine row highlighted |
| 10 | Bone Marrow – Indications + Findings | Split box (when to do it / what it shows) |
| 11 | Diagnostic Algorithm Flowchart | Full flowchart: Hb↓ → Smear+Retic → Retic branch → MCV branch → Tests |
| — | Key Pearls footer | Dark navy strip with 8 high-yield memory anchors |
Create a single page note taking like image of this content and add infographics and illustrations wherever needed for quick understanding (Use generate poster tool)
Generating Image

Here's your single-page diagnostic note poster. It covers all 10 stepwise sections in one visual:
- Header — title + normal Hb reference values by population
- Steps 1–2 — History & Physical Exam side-by-side
- Step 3 — CBC indices quick-reference bar
- Step 4 — Reticulocyte count master branch diamond (High → Hemolysis/Bleeding | Low → Underproduction)
- Step 5 — MCV 3-column classification (Microcytic / Normocytic / Macrocytic) with causes and tests
- Step 6 — Iron studies differential table (IDA vs ACD vs Thal vs Sideroblastic) with key highlights
- Step 7 — Peripheral smear morphology tiles (8 RBC abnormalities → diagnoses)
- Step 8 — Hemolysis workup grid (LDH, haptoglobin, DAT, G6PD, PNH screen)
- Step 9 — B12 vs Folate vs MDS differential table
- Step 10 — Diagnostic algorithm flowchart + Bone marrow indications
- Footer — Severity band + 8 high-yield pearls
This is a shared conversation. Sign in to Orris to start your own chat.